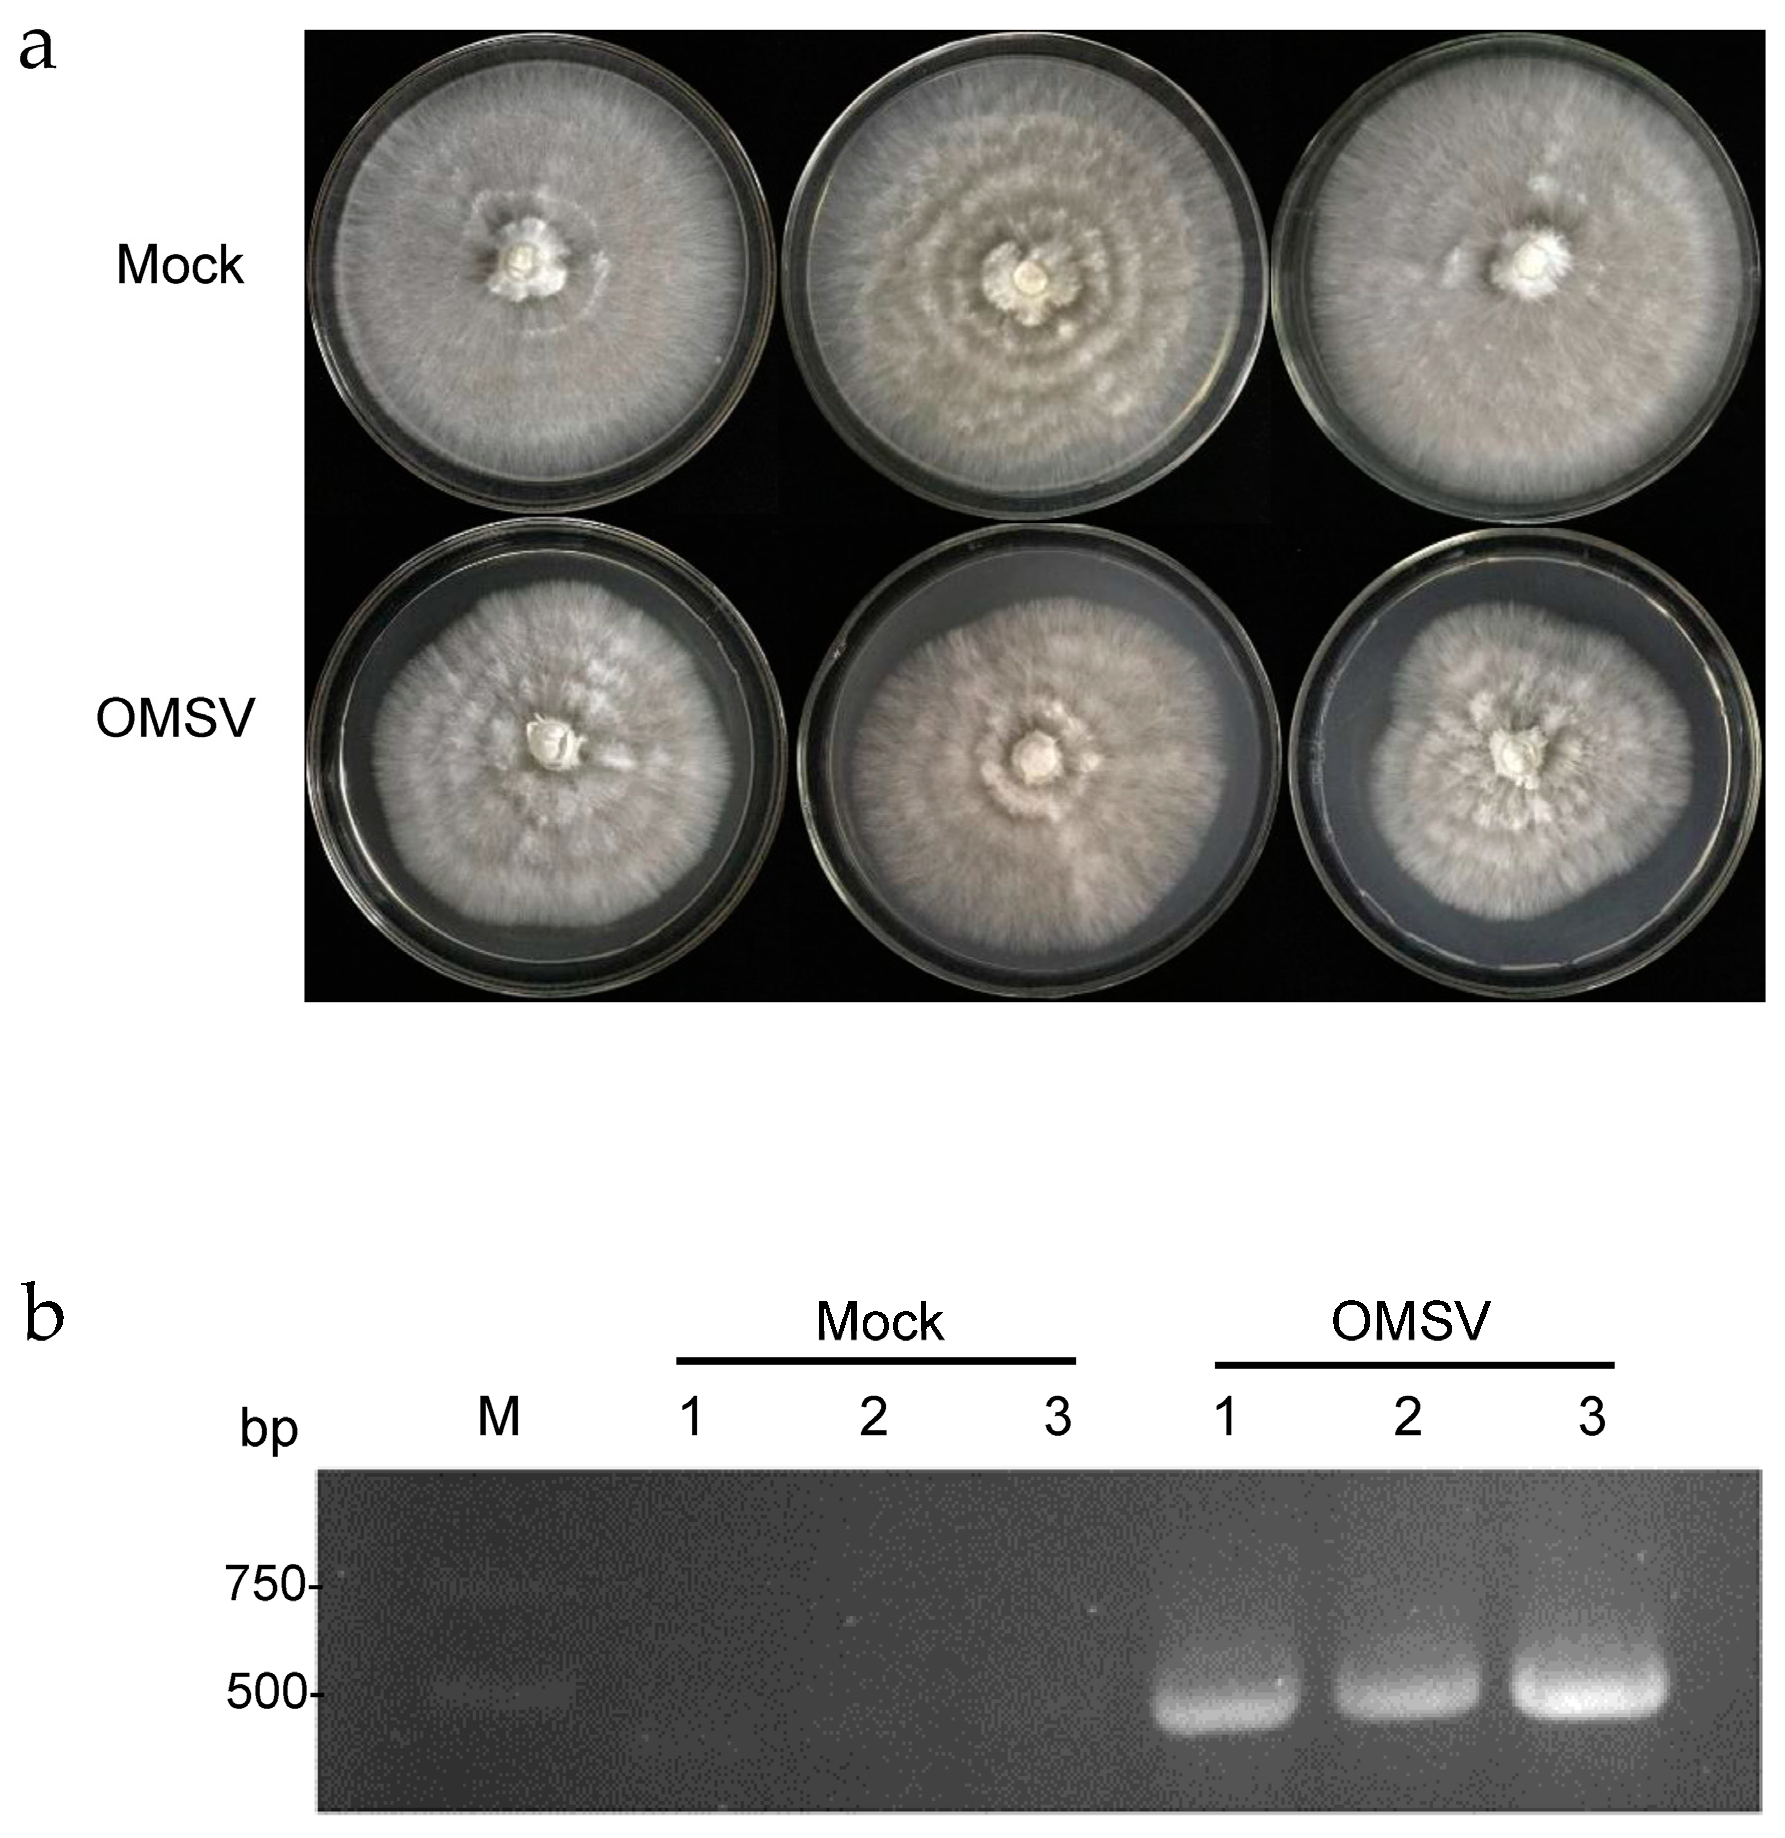
Ijms 25 09749 g001 Ijms 25 09749 g001

Transcriptome Analysis Reveals the Effect of Oyster Mushroom Spherical Virus Infection in Pleurotus ostreatus
Abstract
1. Introduction
2. Results
2.1. Transcriptome Data Assembly Results
2.2. Expression Analysis
2.3. Differential Gene Analysis
2.4. KOG Functional Enrichment Analysis of DEGs
2.5. Gene Ontology and Kyoto Encyclopedia of Genes and Genomes Functional Enrichment Analysis of DEGs
2.6. Quantitative Reverse Transcription-PCR Validation of DEGs
2.7. Effect of OMSV Infection on CAZymes
3. Discussion
4. Materials and Methods
4.1. RNA Extraction
4.2. Reverse Transcription PCR
4.3. cDNA Library Preparation and Illumina Sequencing
4.4. Data Processing and Differential Expression Analysis
4.5. Functional Analysis of DEGs
4.6. Quantitative RT-PCR Validation
4.7. Measurement of Enzyme Activity
5. Conclusions
Author Contributions
Funding
Institutional Review Board Statement
Informed Consent Statement
Data Availability Statement
Acknowledgments
Conflicts of Interest
References
- Doedt, T.; Krishnamurthy, S.; Bockmühl, D.P.; Tebarth, B.; Stempel, C.; Russell, C.L.; Brown, A.J.; Ernst, J.F. APSES proteins regulate morphogenesis and metabolism in Candida albicans. Mol. Biol. Cell 2004, 15, 3167–3180. [Google Scholar] [CrossRef] [PubMed]
- Sahin, E.; Akata, I. Viruses infecting macrofungi. Virusdisease 2018, 29, 1–18. [Google Scholar] [CrossRef]
- Hollings, M. Mycoviruses: Viruses that infect fungi. Adv. Virus Res. 1978, 22, 1–53. [Google Scholar]
- HOLLINGS, M. Viruses Associated with A Die-Back Disease of Cultivated Mushroom. Nature 1962, 196, 962–965. [Google Scholar] [CrossRef]
- Zhang, Y.J.; Gao, J.; Li, Y. Diversity of mycoviruses in edible fungi. Virus Genes 2022, 58, 377–391. [Google Scholar] [CrossRef] [PubMed]
- Nibert, M.L.; Ghabrial, S.A.; Maiss, E.; Lesker, T.; Vainio, E.J.; Jiang, D.; Suzuki, N. Taxonomic reorganization of family Partitiviridae and other recent progress in partitivirus research. Virus Res. 2014, 188, 128–141. [Google Scholar] [CrossRef] [PubMed]
- Ghabrial, S.A.; Castón, J.R.; Jiang, D.; Nibert, M.L.; Suzuki, N. 50-plus years of fungal viruses. Virology 2015, 479–480, 356–368. [Google Scholar] [CrossRef]
- Ghabrial, S.A.; Suzuki, N. Viruses of plant pathogenic fungi. Annu. Rev. Phytopathol. 2009, 47, 353–384. [Google Scholar] [CrossRef]
- Son, M.; Yu, J.; Kim, K.H. Five Questions about Mycoviruses. PLoS Pathog. 2015, 11, e1005172. [Google Scholar] [CrossRef]
- Xie, J.T.; Jiang, D.H. New insights into mycoviruses and exploration for the biological control of crop fungal diseases. Annu. Rev. Phytopathol. 2014, 52, 45–68. [Google Scholar] [CrossRef]
- Sun, X.Y.; Wang, Z.Y.; Gu, Q.S.; Li, H.L.; Han, W.L.; Shi, Y. Transcriptome analysis of Cucumis sativus infected by Cucurbit chlorotic yellows virus. Virol. J. 2017, 14, 18. [Google Scholar] [CrossRef] [PubMed][Green Version]
- Chun, J.; Ko, Y.H.; Kim, D.H. Transcriptome Analysis of Cryphonectria parasitica Infected with Cryphonectria hypovirus 1 (CHV1) Reveals Distinct Genes Related to Fungal Metabolites, Virulence, Antiviral RNA-Silencing, and Their Regulation. Front. Microbiol. 2020, 11, 1711. [Google Scholar] [CrossRef]
- Zhang, Z.K.; Guo, W.B.; Lu, Y.; Kang, Q.; Sui, L.; Liu, H.; Zhao, Y.; Zou, X.W.; Li, Q.Y. Hypovirulence-associated mycovirus epidemics cause pathogenicity degeneration of Beauveria bassiana in the field. Virol. J. 2023, 20, 255. [Google Scholar] [CrossRef]
- Wang, Y.J.; Li, Q.S.; Wu, Y.X.; Han, S.; Xiao, Y.; Kong, L.X. The Effects of Mycovirus BmPV36 on the Cell Structure and Transcription of Bipolaris maydis. J. Fungi 2024, 10, 133. [Google Scholar] [CrossRef] [PubMed]
- O’Connor, E.; Doyle, S.; Amini, A.; Grogan, H.; Fitzpatrick, D.A. Transmission of mushroom virus X and the impact of virus infection on the transcriptomes and proteomes of different strains of Agaricus bisporus. Fungal Biol. 2021, 125, 704–717. [Google Scholar] [CrossRef]
- André, I.; Potocki-Véronèse, G.; Barbe, S.; Moulis, C.; Remaud-Siméon, M. CAZyme discovery and design for sweet dreams. Curr. Opin. Chem. Biol. 2014, 19, 17–24. [Google Scholar] [CrossRef]
- Sista Kameshwar, A.K.; Qin, W. Comparative study of genome-wide plant biomass-degrading CAZymes in white rot, brown rot and soft rot fungi. Mycology 2018, 9, 93–105. [Google Scholar] [CrossRef]
- Rigling, D.; Van Alfen, N.K. Extra- and Intracellular Laccases of the Chestnut Blight Fungus, Cryphonectria parasitica. Appl. Environ. Microbiol. 1993, 59, 3634–3639. [Google Scholar] [CrossRef] [PubMed]
- Song, H.Y.; Kim, N.; Kim, D.H.; Kim, J.M. The PoV mycovirus affects extracellular enzyme expression and fruiting body yield in the oyster mushroom, Pleurotus ostreatus. Sci. Rep. 2020, 10, 1094. [Google Scholar] [CrossRef]
- Hoa, H.T.; Wang, C.L.; Wang, C.H. The Effects of Different Substrates on the Growth, Yield, and Nutritional Composition of Two Oyster Mushrooms (Pleurotus ostreatus and Pleurotus cystidiosus). Mycobiology 2015, 43, 423–434. [Google Scholar] [CrossRef]
- Chorváthová, V.; Bobek, P.; Ginter, E.; Klvanová, J. Effect of the oyster fungus on glycaemia and cholesterolaemia in rats with insulin-dependent diabetes. Physiol. Res. 1993, 42, 175–179. [Google Scholar] [PubMed]
- Lim, W.S.; Jeong, J.H.; Jeong, R.D.; Yoo, Y.B.; Yie, S.W.; Kim, K.H. Complete nucleotide sequence and genome organization of a dsRNA partitivirus infecting Pleurotus ostreatus. Virus Res. 2005, 108, 111–119. [Google Scholar] [CrossRef] [PubMed]
- Ro, H.S.; Lee, N.J.; Lee, C.W.; Lee, H.S. Isolation of a novel mycovirus OMIV in Pleurotus ostreatus and its detection using a triple antibody sandwich-ELISA. J. Virol. Methods 2006, 138, 24–29. [Google Scholar] [CrossRef]
- Qiu, L.Y.; Li, Y.P.; Liu, Y.M.; Gao, Y.Q.; Qi, Y.C.; Shen, J.W. Particle and naked RNA mycoviruses in industrially cultivated mushroom Pleurotus ostreatus in China. Fungal Biol. 2010, 114, 507–513. [Google Scholar] [CrossRef] [PubMed]
- Kim, Y.J.; Kim, J.Y.; Kim, J.H.; Yoon, S.M.; Yoo, Y.B.; Yie, S.W. The identification of a novel Pleurotus ostreatus dsRNA virus and determination of the distribution of viruses in mushroom spores. J. Microbiol. 2008, 46, 95–99. [Google Scholar] [CrossRef] [PubMed]
- Song, H.Y.; Choi, H.J.; Jeong, H.; Choi, D.; Kim, D.H.; Kim, J.M. Viral Effects of a dsRNA Mycovirus (PoV-ASI2792) on the Vegetative Growth of the Edible Mushroom Pleurotus ostreatus. Mycobiology 2016, 44, 283–290. [Google Scholar] [CrossRef]
- Xiao, J.B.; Wang, X.; Zheng, Z.R.; Wu, Y.G.; Wang, Z.; Li, H.P.; Li, P.F. Molecular characterization of a novel deltaflexivirus infecting the edible fungus Pleurotus ostreatus. Arch. Virol. 2023, 168, 162. [Google Scholar] [CrossRef]
- Yu, H.J.; Lim, D.; Lee, H.S. Characterization of a novel single-stranded RNA mycovirus in Pleurotus ostreatus. Virology 2003, 314, 9–15. [Google Scholar] [CrossRef]
- Li, S.; Dai, J.; Zhang, Y.J.; Li, Y. Cloning of Coat Protein Gene of Oyster Mushroom Spherical Virus and Preliminary Analysis of Viral Pathogenicity. J. Northeast Agric. Sci. 2022, 47, 43–47. [Google Scholar]
- Shi, Y.C.; Xie, A.T.; Wang, X.L.; Wang, S.J.; Liu, X.D.; Zhou, T. Detection of oyster mushroom spherical virus in Beijing and its controlling measures. China Plant Prot. 2016, 36, 9–11+21+81. [Google Scholar]
- Hu, H.J.; Wang, J.R.; Cheng, X.H.; Liu, Y.; Zhang, X.Y. Preliminary Studies on the Effects of Oyster Mushroom Spherical Virus China Strain on the Mycelial Growth and Fruiting Body Yield of the Edible Mushroom Pleurotus ostreatus. Biology 2022, 11, 574. [Google Scholar] [CrossRef] [PubMed]
- Zhang, X.Y.; Hu, H.J.; Zhao, Y.X.; Wang, Y.F.; Zhang, W.J.; You, L.H.; Wang, J.R.; Liu, Y.; Cheng, X.H. Oyster Mushroom Spherical Virus Crosses the Species Barrier and Is Pathogenic to a New Host Pleurotus pulmonarius. Int. J. Mol. Sci. 2023, 24, 10584. [Google Scholar] [CrossRef]
- Wang, Y.F.; Wen, Z.D.; Yang, Y.Y.; Hu, X.T.; Song, Z.Z.; Hu, H.J.; Song, G.Y.; You, L.H.; Wang, J.R.; Liu, Y.; et al. Transmission of Oyster Mushroom Spherical Virus to Progeny via Basidiospores and Horizontally to a New Host Pleurotus floridanus. Int. J. Mol. Sci. 2024, 25, 5677. [Google Scholar] [CrossRef] [PubMed]
- Singh, R.S.; Walia, A.K.; Kennedy, J.F. Mushroom lectins in biomedical research and development. Int. J. Biol. Macromol. 2020, 151, 1340–1350. [Google Scholar] [CrossRef] [PubMed]
- Dawe, A.L.; Nuss, D.L. Hypoviruses and chestnut blight: Exploiting viruses to understand and modulate fungal pathogenesis. Annu. Rev. Genet. 2001, 35, 1–29. [Google Scholar] [CrossRef][Green Version]
- Peng, Y.J.; Hou, J.; Zhang, H.; Lei, J.H.; Lin, H.Y.; Ding, J.L.; Feng, M.G.; Ying, S.H. Systematic contributions of CFEM domain-containing proteins to iron acquisition are essential for interspecies interaction of the filamentous pathogenic fungus Beauveria bassiana. Environ. Microbiol. 2022, 24, 3693–3704. [Google Scholar] [CrossRef]
- Haas, H. Fungal siderophore metabolism with a focus on Aspergillus fumigatus. Nat. Prod. Rep. 2014, 31, 1266–1276. [Google Scholar] [CrossRef]
- Roy, U.; Kornitzer, D. Heme-iron acquisition in fungi. Curr. Opin. Microbiol. 2019, 52, 77–83. [Google Scholar] [CrossRef] [PubMed]
- Pinsky, M.; Roy, U.; Moshe, S.; Weissman, Z.; Kornitzer, D. Human Serum Albumin Facilitates Heme-Iron Utilization by Fungi. mBio 2020, 11, e00607-20. [Google Scholar] [CrossRef]
- Liu, Q.; Dong, C. Dual Transcriptomics Reveals Interspecific Interactions between the Mycoparasite Calcarisporium cordycipiticola and Its Host Cordyceps militaris. Microbiol. Spectr. 2023, 11, e0480022. [Google Scholar] [CrossRef]
- Aliferis, K.A.; Faubert, D.; Jabaji, S. A metabolic profiling strategy for the dissection of plant defense against fungal pathogens. PLoS ONE 2014, 9, e111930. [Google Scholar] [CrossRef] [PubMed]
- García-Pedrajas, M.D.; Cañizares, M.C.; Sarmiento-Villamil, J.L.; Jacquat, A.G.; Dambolena, J.S. Mycoviruses in Biological Control: From Basic Research to Field Implementation. Phytopathology 2019, 109, 1828–1839. [Google Scholar] [CrossRef] [PubMed]
- Nerva, L.; Chitarra, W.; Siciliano, I.; Gaiotti, F.; Ciuffo, M.; Forgia, M.; Varese, G.C.; Turina, M. Mycoviruses mediate mycotoxin regulation in Aspergillus ochraceus. Environ. Microbiol. 2019, 21, 1957–1968. [Google Scholar] [CrossRef]
- Li, H.P.; Yang, W.J.; Qu, S.X.; Pei, F.; Luo, X.; Mariga, A.M.; Ma, L. Variation of volatile terpenes in the edible fungi mycelia Flammulina velutipes and communications in fungus-mite interactions. Food Res. Int. 2018, 103, 150–155. [Google Scholar] [CrossRef] [PubMed]
- Ding, F.; Cheng, J.S.; Fu, Y.P.; Chen, T.; Li, B.; Jiang, D.H.; Xie, J.T. Early Transcriptional Response to DNA Virus Infection in Sclerotinia sclerotiorum. Viruses 2019, 11, 278. [Google Scholar] [CrossRef]
- Liu, Q.H.; Wang, H.X.; Ng, T.B. Isolation and characterization of a novel lectin from the wild mushroom Xerocomus spadiceus. Peptides 2004, 25, 7–10. [Google Scholar] [CrossRef]
- Pohleven, J.; Obermajer, N.; Sabotic, J.; Anzlovar, S.; Sepcić, K.; Kos, J.; Kralj, B.; Strukelj, B.; Brzin, J. Purification, characterization and cloning of a ricin B-like lectin from mushroom Clitocybe nebularis with antiproliferative activity against human leukemic T cells. Biochim. Biophys. Acta 2009, 1790, 173–181. [Google Scholar] [CrossRef]
- Kim, S. A novel core 1 O-linked glycan-specific binding lectin from the fruiting body of Hericium erinaceus. Int. J. Biol. Macromol. 2018, 107 Pt B, 1528–1537. [Google Scholar] [CrossRef]
- Singh, S.S.; Wang, H.; Chan, Y.S.; Pan, W.; Dan, X.; Yin, C.M.; Akkouh, O.; Ng, T.B. Lectins from edible mushrooms. Molecules 2014, 20, 446–469. [Google Scholar] [CrossRef]
- Imberty, A.; Mitchell, E.P.; Wimmerová, M. Structural basis of high-affinity glycan recognition by bacterial and fungal lectins. Curr. Opin. Struct. Biol. 2005, 15, 525–534. [Google Scholar] [CrossRef]
- Bleuler-Martinez, S.; Stutz, K.; Sieber, R.; Collot, M.; Mallet, J.M.; Hengartner, M.; Schubert, M.; Varrot, A.; Künzler, M. Dimerization of the fungal defense lectin CCL2 is essential for its toxicity against nematodes. Glycobiology 2017, 27, 486–500. [Google Scholar] [CrossRef] [PubMed]
- Tayyrov, A.; Schmieder, S.S.; Bleuler-Martinez, S.; Plaza, D.F.; Künzler, M. Toxicity of Potential Fungal Defense Proteins towards the Fungivorous Nematodes Aphelenchus avenae and Bursaphelenchus okinawaensis. Appl. Environ. Microbiol. 2018, 84, e02051-18. [Google Scholar] [CrossRef] [PubMed]
- Alborés, S.; Mora, P.; Bustamante, M.J.; Cerdeiras, M.P.; Franco Fraguas, L. Purification and applications of a lectin from the mushroom Gymnopilus spectabilis. Appl. Biochem. Biotechnol. 2014, 172, 2081–2090. [Google Scholar] [CrossRef]
- Liu, J.J.; Li, H.P.; Luo, X.; Ma, L.; Li, C.X.; Qu, S.X. A lectin gene is involved in the defense of Pleurotus ostreatus against the mite predator Tyrophagus putrescentiae. Front. Microbiol. 2023, 14, 1191500. [Google Scholar] [CrossRef]
- Shen, C.Y.; Li, Y.T.; Liu, X.M.; Wang, Y.H.; Feng, Z.G.; Shi, Y. Effect of Selenium on Extracellular Enzyme Activities of Pleurotus ostreatus. J. Anhui Agric. Sci. 2023, 51, 42–44+56. [Google Scholar]
- Yu, X.; Li, B.; Fu, Y.; Jiang, D.H.; Ghabrial, S.A.; Li, G.Q.; Peng, Y.L.; Xie, J.T.; Cheng, J.S.; Huang, J.B.; et al. A geminivirus-related DNA mycovirus that confers hypovirulence to a plant pathogenic fungus. Proc. Natl. Acad. Sci. USA 2010, 107, 8387–8392. [Google Scholar] [CrossRef] [PubMed]
- Yu, X.; Li, B.; Fu, Y.; Xie, J.T.; Cheng, J.S.; Ghabrial, S.A.; Li, G.Q.; Yi, X.H.; Jiang, D.H. Extracellular transmission of a DNA mycovirus and its use as a natural fungicide. Proc. Natl. Acad. Sci. USA 2013, 110, 1452–1457. [Google Scholar] [CrossRef]
- Lombard, V.; Golaconda Ramulu, H.; Drula, E.; Coutinho, P.M.; Henrissat, B. The carbohydrate-active enzymes database (CAZy) in 2013. Nucleic Acids Res. 2014, 42, D490–D495. [Google Scholar] [CrossRef]
- Levasseur, A.; Drula, E.; Lombard, V.; Coutinho, P.M.; Henrissat, B. Expansion of the enzymatic repertoire of the CAZy database to integrate auxiliary redox enzymes. Biotechnol. Biofuels 2013, 6, 41. [Google Scholar] [CrossRef]
- Ali, M.; Li, Q.H.; Zou, T.; Wei, A.M.; Gombojab, G.; Lu, G.; Gong, Z.H. Chitinase Gene Positively Regulates Hypersensitive and Defense Responses of Pepper to Colletotrichum acutatum Infection. Int. J. Mol. Sci. 2020, 21, 6624. [Google Scholar] [CrossRef]
- Chen, J.Y.; Sang, H.; Chilvers, M.I.; Wu, C.H.; Chang, H.X. Characterization of soybean chitinase genes induced by rhizobacteria involved in the defense against Fusarium oxysporum. Front. Plant Sci. 2024, 15, 1341181. [Google Scholar] [CrossRef] [PubMed]
- Shah, U.A.; Kotta-Loizou, I.; Fitt, B.D.L.; Coutts, R.H.A. Mycovirus-Induced Hypervirulence of Leptosphaeria biglobosa Enhances Systemic Acquired Resistance to Leptosphaeria maculans in Brassica napus. Mol. Plant-Microbe Interact. MPMI 2020, 33, 98–107. [Google Scholar] [CrossRef]
- Trapnell, C.; Williams, B.A.; Pertea, G.; Mortazavi, A.; Kwan, G.; van Baren, M.J.; Salzberg, S.L.; Wold, B.J.; Pachter, L. Transcript assembly and quantification by RNA-Seq reveals unannotated transcripts and isoform switching during cell differentiation. Nat. Biotechnol. 2010, 28, 511–515. [Google Scholar] [CrossRef] [PubMed]
- Love, M.I.; Huber, W.; Anders, S. Moderated estimation of fold change and dispersion for RNA-seq data with DESeq2. Genome Biol. 2014, 15, 550. [Google Scholar] [CrossRef] [PubMed]
- Manavalan, A.; Manavalan, T.; Murugesan, K.; Kutzner, A.; Thangavelu, K.P.; Heese, K. Characterization of a solvent, surfactant and temperature-tolerant laccase from Pleurotus sp. MAK-II and its dye decolorizing property. Biotechnol. Lett. 2015, 37, 2403–2409. [Google Scholar] [CrossRef]
- König, J.; Grasser, R.; Pikor, H.; Vogel, K. Determination of xylanase, beta-glucanase, and cellulase activity. Anal. Bioanal. Chem. 2002, 374, 80–87. [Google Scholar]
- Yin, D.; Deng, X.; Chet, I.; Song, R. Physiological responses of Pinus sylvestris var. mongolica seedlings to the interaction between Suillus luteus and Trichoderma Virens. Curr. Microbiol. 2014, 69, 334–342. [Google Scholar]
- Zaferanloo, B.; Bhattacharjee, S.; Ghorbani, M.M.; Mahon, P.J.; Palombo, E.A. Amylase production by Preussia minima, a fungus of endophytic origin: Optimization of fermentation conditions and analysis of fungal secretome by LC-MS. BMC Microbiol. 2014, 14, 55. [Google Scholar] [CrossRef]

| Samples | Clean Reads | Clean Bases | GC Content | % ≥ Q30 |
|---|---|---|---|---|
| Mock-1 | 20,965,286 | 6,276,707,342 | 53.67% | 92.68% |
| Mock-2 | 23,424,577 | 7,016,262,210 | 53.80% | 94.51% |
| Mock-3 | 22,083,023 | 6,613,712,742 | 53.68% | 92.63% |
| OMSV-1 | 24,515,659 | 7,343,439,530 | 54.18% | 94.47% |
| OMSV-2 | 24,050,037 | 7,202,732,604 | 54.08% | 94.54% |
| OMSV-3 | 22,548,293 | 6,753,639,986 | 54.24% | 94.88% |
| Pathway | DEGs with Pathway Annotation | Pathway ID | p-Value |
|---|---|---|---|
| Glyoxylate and dicarboxylate metabolism | 6 (6.12%) | ko00630 | 0.000953 |
| Glycine, serine, and threonine metabolism | 9 (9.18%) | ko00260 | 0.000997 |
| Fatty acid biosynthesis | 5 (5.10%) | ko00061 | 0.003113 |
| Penicillin and cephalosporin biosynthesis | 2 (2.04%) | ko00311 | 0.005509 |
| D-Arginine and D-ornithine metabolism | 2 (2.04%) | ko00472 | 0.005509 |
| Propanoate metabolism | 5 (5.10%) | ko00640 | 0.008949 |
| One carbon pool by folate | 3 (3.06%) | ko00670 | 0.010096 |
| Phenylalanine, tyrosine, and tryptophan biosynthesis | 3 (3.06%) | ko00400 | 0.014425 |
| Non-homologous end-joining | 3 (3.06%) | ko03450 | 0.014425 |
| Cutin, suberine, and wax biosynthesis | 2 (2.04%) | ko00073 | 0.018137 |
| Genes | Annotation | log2FoldChange | 2−ΔΔCt |
|---|---|---|---|
| g1073569 | Methylenetetrahydrofolate dehydrogenase | −1.92 | 0.97 |
| g1052256 | S-adenosylmethionine synthetase | −1.48 | 0.34 |
| g1047319 | Polyketide synthase | −3.64 | 0.80 |
| g1073665 | Aryl-alcohol dehydrogenase | −1.93 | 0.05 |
| g1088328 | Enoyl-(Acyl carrier protein) reductase | 1.70 | 2.16 |
| g1113424 | Cytochrome P450 | −2.14 | 0.18 |
| g1074848 | Chitinase | 1.75 | 1.32 |
| g1077485 | Nicotinate-nucleotide pyrophosphorylase | −0.70 | 0.85 |
| g1088664 | 1,3-beta-glucosidase | 0.66 | 1.26 |
| g1103527 | Beta-glucan synthesis-associated protein | −0.82 | 0.64 |
| g1036297 | Polysaccharide lyase family 8 protein | 1.03 | 2.29 |
| g51725 | Laccase | −0.60 | 0.77 |
| g1067151 | Chitin synthase | −2.41 | 0.09 |
| g1044280 | Lipase | 1.96 | 1.06 |
| g1046093 | 50S ribosome-binding GTPase | 3.50 | 5.81 |
| Gene ID | Forward Primer (5′→3′) | Reverse Primer (5′→3′) | Size (bp) |
|---|---|---|---|
| g1073569 | GAAGTCGGAGGCCGTATCAG | CATACGTCGAGGAATCGGGG | 103 |
| g1052256 | TGGTCACCACTGTCGTCTTG | CGATGCGTGTAGAAGGTGGT | 114 |
| g1047319 | TGACCGCTCGCAGACAAAT | CTTCTCGATAAGCTCAGCCTTGG | 74 |
| g1088328 | TTGTTACCGGCCAGGTGATG | AAACATCGAGTTTGCATCGCT | 76 |
| g1044280 | TTTCTGGGTTTCCACCACCC | TCTTGGCCTGGACAGGAAAC | 80 |
| g1073665 | ACAGTTCATCGGTGAGTGGG | GCCGTGTACTTGGTCGAGATA | 72 |
| g1067151 | GGGAGCTGCTTTGGATGAGT | ACTGTGAGGCACAGCGATAG | 86 |
| g1113424 | AGTGGCAGGTTCTTGGTCTG | CAAAGGTAAGGCGAACGACG | 115 |
| g1046093 | TGGATCTTCCTGAAACCGCC | TAGCACGAGGGAAGAGTTAAGTG | 145 |
| g1074848 | TTCGGGCACATCTTATTGGGG | ATCGATGGAATCGTCCTGGC | 106 |
| g1077485 | ATGTTCGTCGTGGCACTTCT | CAGCGATATGAGAGTGGCGT | 100 |
| g1088664 | CCCATCGTCTCAGCCTTCAA | ACTCTACTCACGGTCTGCGA | 91 |
| g1103527 | ACCTCGGTTTCTCTCCCAGG | GCTCTGCCGAGATTACCCAT | 80 |
| g1036297 | TGGTACACCGTGGACGCAAT | CATTCTGTGTTGACGGTGCG | 70 |
| g51725 | GGATGGATACAGTCGCCAGG | CAATCTGAAGGTGTCGCCCT | 88 |
Disclaimer/Publisher’s Note: The statements, opinions and data contained in all publications are solely those of the individual author(s) and contributor(s) and not of MDPI and/or the editor(s). MDPI and/or the editor(s) disclaim responsibility for any injury to people or property resulting from any ideas, methods, instructions or products referred to in the content. |
© 2024 by the authors. Licensee MDPI, Basel, Switzerland. This article is an open access article distributed under the terms and conditions of the Creative Commons Attribution (CC BY) license (https://creativecommons.org/licenses/by/4.0/).
Share and Cite
Wang, Y.; Yan, J.; Song, G.; Song, Z.; Shi, M.; Hu, H.; You, L.; Zhang, L.; Wang, J.; Liu, Y.; et al. Transcriptome Analysis Reveals the Effect of Oyster Mushroom Spherical Virus Infection in Pleurotus ostreatus. Int. J. Mol. Sci. 2024, 25, 9749. https://doi.org/10.3390/ijms25179749
Wang Y, Yan J, Song G, Song Z, Shi M, Hu H, You L, Zhang L, Wang J, Liu Y, et al. Transcriptome Analysis Reveals the Effect of Oyster Mushroom Spherical Virus Infection in Pleurotus ostreatus. International Journal of Molecular Sciences. 2024; 25(17):9749. https://doi.org/10.3390/ijms25179749
Chicago/Turabian StyleWang, Yifan, Junjie Yan, Guoyue Song, Zhizhong Song, Matthew Shi, Haijing Hu, Lunhe You, Lu Zhang, Jianrui Wang, Yu Liu, and et al. 2024. "Transcriptome Analysis Reveals the Effect of Oyster Mushroom Spherical Virus Infection in Pleurotus ostreatus" International Journal of Molecular Sciences 25, no. 17: 9749. https://doi.org/10.3390/ijms25179749
APA StyleWang, Y., Yan, J., Song, G., Song, Z., Shi, M., Hu, H., You, L., Zhang, L., Wang, J., Liu, Y., Cheng, X., & Zhang, X. (2024). Transcriptome Analysis Reveals the Effect of Oyster Mushroom Spherical Virus Infection in Pleurotus ostreatus. International Journal of Molecular Sciences, 25(17), 9749. https://doi.org/10.3390/ijms25179749

